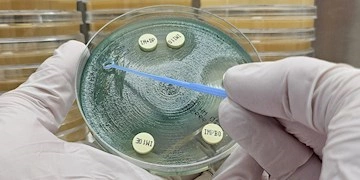
Antibiotikaresistens

Infektionshygiejniske retningslinjer for MRSA
Methicillinresistente Staphylococcus aureus (MRSA)
MRSA er stafylokokker, der er modstandsdygtige/resistente over for de antibiotika, som sædvanligvis anvendes til behandling af stafylokokinfektioner. MRSA er således resistente over for alle β-laktamantibiotika (penicilliner, cefalosporiner, carbapenemer).
I sammenligning med mange andre lande har Danmark fortsat en lav forekomst af MRSA, men siden 2003 er der set en kraftig stigning i antallet af nye tilfælde af MRSA. Sideløbende med denne stigning er der set en ændring i forekomsten. Hvor MRSA tidligere næsten udelukkende var et hospitalsfænomen, så er hovedparten af tilfældene nu samfundserhvervede og optræder således hos personer uden kontakt til hospitalerne. En del af denne stigning skyldes en ny MRSA-type (MRSA-type CC398), der har sit primære reservoir i grise og herfra især smitter til mennesker med kontakt til levende grise. MRSA-typen CC398 udgør ca. 1/5 af alle nye tilfælde på landsplan. Antallet af MRSA-tilfælde erhvervet i udlandet (importerede tilfælde) har ligeledes været i stigning gennem årene, dog sås et fald under covid-19-pandemien.
Sundhedsstyrelsens nationale MRSA-vejledning blev udgivet første gang i 2006. Gældende udgave kan læses her: "Vejledning om forebyggelse af spredning af MRSA", 3. udgave 2016
Infektionshygiejniske retningslinjer
Hospitaler
Download dokumentet Infektionshygiejniske retningslinjer: Hospitaler (pdf-format)
Plejeboliger og lignende institutioner
Download dokumentet Infektionshygiejniske retningslinjer: Plejeboliger og lignende institutioner (pdf-format)
Hjemmepleje og hjemmesygepleje
Download dokumenter Infektionshygiejniske retningslinjer: Hjemmepleje og hjemmesygepleje (pdf-format)
Klinikker, herunder tandlægeklinikker
Download dokumentet Infektionshygiejniske retningslinjer: Klinikker, herunder tandlægeklinikker (pdf-format)
Sundhedsplejersker
Download dokumentet Infektionshygiejniske retningslinjer: Sundhedsplejersker (pdf-format)
Informationsbreve
Vejledning til forældre hvor der er fundet MRSA hos nyfødte og børn op til 2 år
Information til dig der har fået konstateret MRSA
Hudplejeprodukter som kan anvendes sammen med klorhexidinsæbe
Nogle hudcremer nedsætter virkningen af klorhexidin. Dette har betydning i forbindelse med behandling for stafylokokbærertilstand, som blandt andet består i helkropsvask med klorhexidinsæbe. Denne liste omfatter danske og udenlandske produkter. Listen opdateres jævnligt på baggrund af oplysninger fra producenter og forhandlere.
Hudplejeprodukter (pdf-format)
Anden information
Rådgivningstjenesten om husdyr-MRSA
Årlige MRSA-opgørelser udgives i EPI-NYT, se www.ssi.dk/aktuelt/nyhedsbreve/epi-nyt
Årlige DANMAP-rapporter, se www.danmap.org
Læs mere
Sundhedsstyrelsens MRSA-side. Her finder du også informationsbrev, oversat til engelsk, polsk, arabisk mfl. under "Supplerende information".